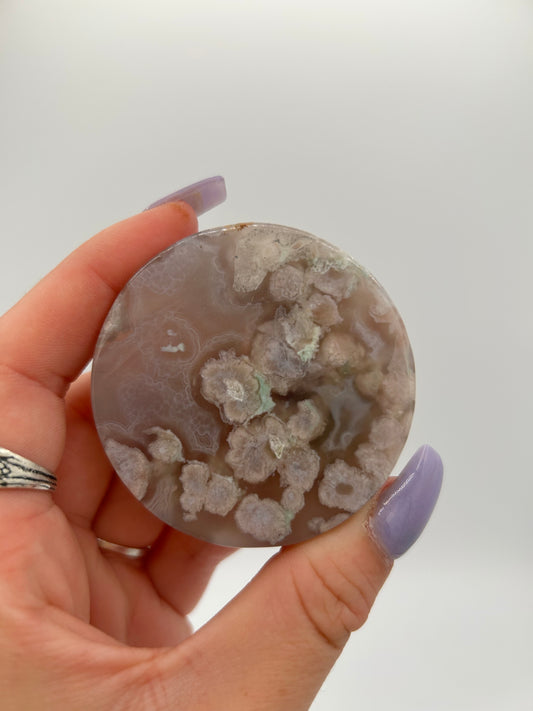
Flower Agate Circle

-
 Sold out
Sold outChlorite Phantom Quartz
Regular price $20.00 USDRegular priceUnit price per -
Chlorite Phantom Quartz
Regular price $45.00 USDRegular priceUnit price per -
 Sold out
Sold outChlorite Phantom Quartz Point
Regular price $45.00 USDRegular priceUnit price per -
Chlorite Phantom Quartz
Regular price $45.00 USDRegular priceUnit price per -
Chlorite Phantom Quartz Cluster
Regular price $100.00 USDRegular priceUnit price per -
Golden Healer Quartz Cluster
Regular price $90.00 USDRegular priceUnit price per -
Clear Quartz cluster
Regular price $700.00 USDRegular priceUnit price per -
 Sold out
Sold outWavellite Specimen
Regular price $50.00 USDRegular priceUnit price per -
Wulfenite with Mimetite
Regular price $150.00 USDRegular priceUnit price per -
Pink Tourmaline
Regular price $48.00 USDRegular priceUnit price per -
Golden Mica in Calcite
Regular price $30.00 USDRegular priceUnit price per -
Flower Agate Circle
Regular price $33.00 USDRegular priceUnit price per -
Titanium Aura Quartz
Regular price $40.00 USDRegular priceUnit price per -
Lemurian Quartz Cluster
Regular price $300.00 USDRegular priceUnit price per -
Lemurian Light Crystal
Regular price $300.00 USDRegular priceUnit price per